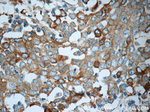
TrpRS Antibody in Immunohistochemistry (Paraffin) (IHC (P))

Search
Proteintech
TrpRS Polyclonal Antibody
{{$productOrderCtrl.translations['antibody.pdp.commerceCard.promotion.promotions']}}
{{$productOrderCtrl.translations['antibody.pdp.commerceCard.promotion.viewpromo']}}
{{$productOrderCtrl.translations['antibody.pdp.commerceCard.promotion.promocode']}}: {{promo.promoCode}} {{promo.promoTitle}} {{promo.promoDescription}}. {{$productOrderCtrl.translations['antibody.pdp.commerceCard.promotion.learnmore']}}
产品信息
16081-1-AP
种属反应
宿主/亚型
分类
类型
抗原
偶联物
形式
浓度
规格
纯化类型
保存液
内含物
保存条件
运输条件
产品详细信息
Immunogen sequence: MPNSEPASL LELFNSIATQ GELVRSLKAG NASKDEIDSA VKMLVSLKMS YKAAAGEDYK ADCPPGNPAP TSNHGPDATE AEEDFVDPWT VQTSSAKGID YDKLIVRFGS SKIDKELINR IERATGQRPH HFLRRGIFFS HRDMNQVLDA YENKKPFYLY TGRGPSSEAM HVGHLIPFIF TKWLQDVFNV PLVIQMTDDE KYLWKDLTLD QAYSYAVENA KDIIACGFDI NKTFIFSDLD YMGMSSGFYK NVVKIQKHVT FNQVKGIFGF TDSDCIGKIS FPAIQAAPSF SNSFPQIFRD RTDIQCLIPC AIDQDPYFRM TRDVAPRIGY PKPALLHSTF FPALQGAQTK MSASDPNSSI FLTDTAKQI (1-368 aa encoded by BC017489 )
靶标信息
Aminoacyl-tRNA synthetases catalyze the aminoacylation of tRNA by their cognate amino acid. Because of their central role in linking amino acids with nucleotide triplets contained in tRNAs, aminoacyl-tRNA synthetases are thought to be among the first proteins that appeared in evolution. Two forms of tryptophanyl-tRNA synthetase exist, a cytoplasmic form, named WARS, and a mitochondrial form, named WARS2. Tryptophanyl-tRNA synthetase (WARS) catalyzes the aminoacylation of tRNA(trp) with tryptophan and is induced by interferon. Tryptophanyl-tRNA synthetase belongs to the class I tRNA synthetase family. Four transcript variants encoding two different isoforms have been found for this gene.
仅用于科研。不用于诊断过程。未经明确授权不得转售。
生物信息学
蛋白别名: epididymis secretory sperm binding protein; hWRS; IFI 53; IFP 53; IFP53; Interferon-induced protein 53; TrpRS; tryptophan tRNA ligase 1, cytoplasmic; Tryptophan--tRNA ligase, cytoplasmic; Tryptophanyl-tRNA synthetase; tryptophanyl-tRNA synthetase, cytoplasmic; unnamed protein product; WARS protein
基因别名: GAMMA-2; HMN9; HMND9; IFI53; IFP53; NEDMSBA; TrpRS; WARS; WARS1; WRS
UniProt ID: (Human) P23381, (Mouse) P32921
Entrez Gene ID: (Human) 7453, (Rat) 314442, (Mouse) 22375